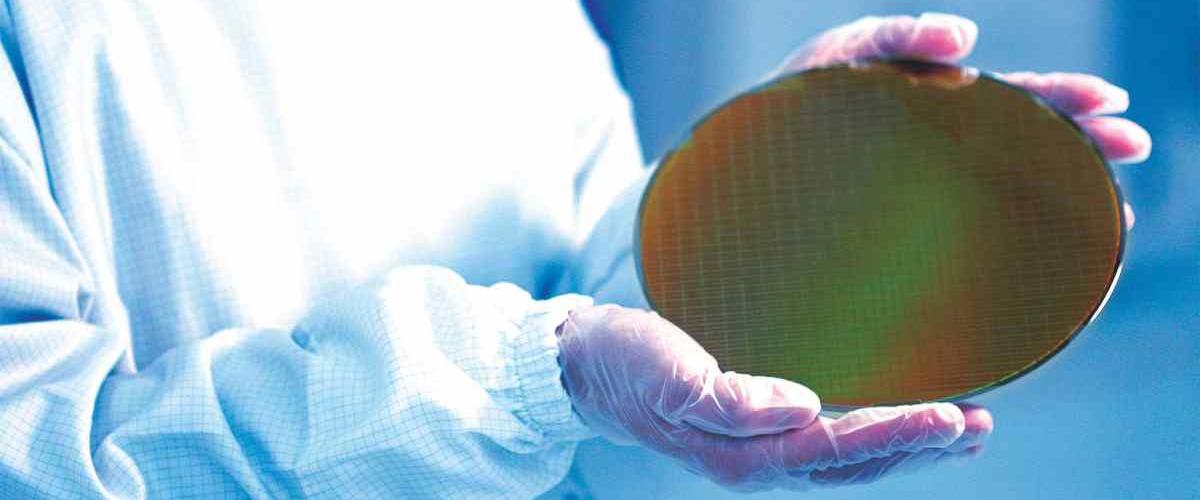
TODO:

Согласно бизнес-отчету, опубликованному 12 марта, Samsung Electronics начнет массовое производство чипов по 4-нм техпроцессу 2-го и 3-го поколения в первой половине этого года. Новые продукты демонстрируют лучшую производительность, меньшее энергопотребление и занимают меньшую площадь по сравнению с SF4E, ранней версией 4-нм чипов. Даже после коммерциализации чипа SF4E Samsung Electronics не удавалось поддерживать выход продукции на должном уровне, что привело к потере крупнейшего клиента — Qualcomm, который перешел к TSMC.
Инсайдеры отрасли оценивают процент выхода качественных 4-нм чипов Samsung Electronics в 60%, тогда как у TSMC она находится в диапазоне 70-80%. Но эксперты говорят, что южнокорейский производитель быстро уменьшает количество брака и массовое производство следующей версии чипа также ускорится.
Поскольку Samsung Electronics добилась прорыва в решении технических задач, ожидается, что ее конкуренция с TSMC обострится в массовом производстве ультрамикротехнологий для 5-нм и более продвинутых чипов.
TSMC планирует начать массовое производство 4-нм чипов на своем заводе в Аризоне, запуск которого запланирован на 2024 год. Samsung Electronics также строит 4-нм производственную линию на своем литейном заводе в Техасе с целью начать производство в США во второй половине 2024 года.
Самый передовой полупроводниковый техпроцесс, который освоен серийно — это 3 нанометра, но основная продукция по-прежнему приходится на 4- и 5-нм чипы. По данным исследовательской фирмы Counterpoint Research, по состоянию на III квартал прошлого года на долю 4- и 5-нм чипов приходилось 22% продаж, на 6- и 7-нм чипы — 16% и на 16-, 14- и 12-нм чипы — еще 11%.